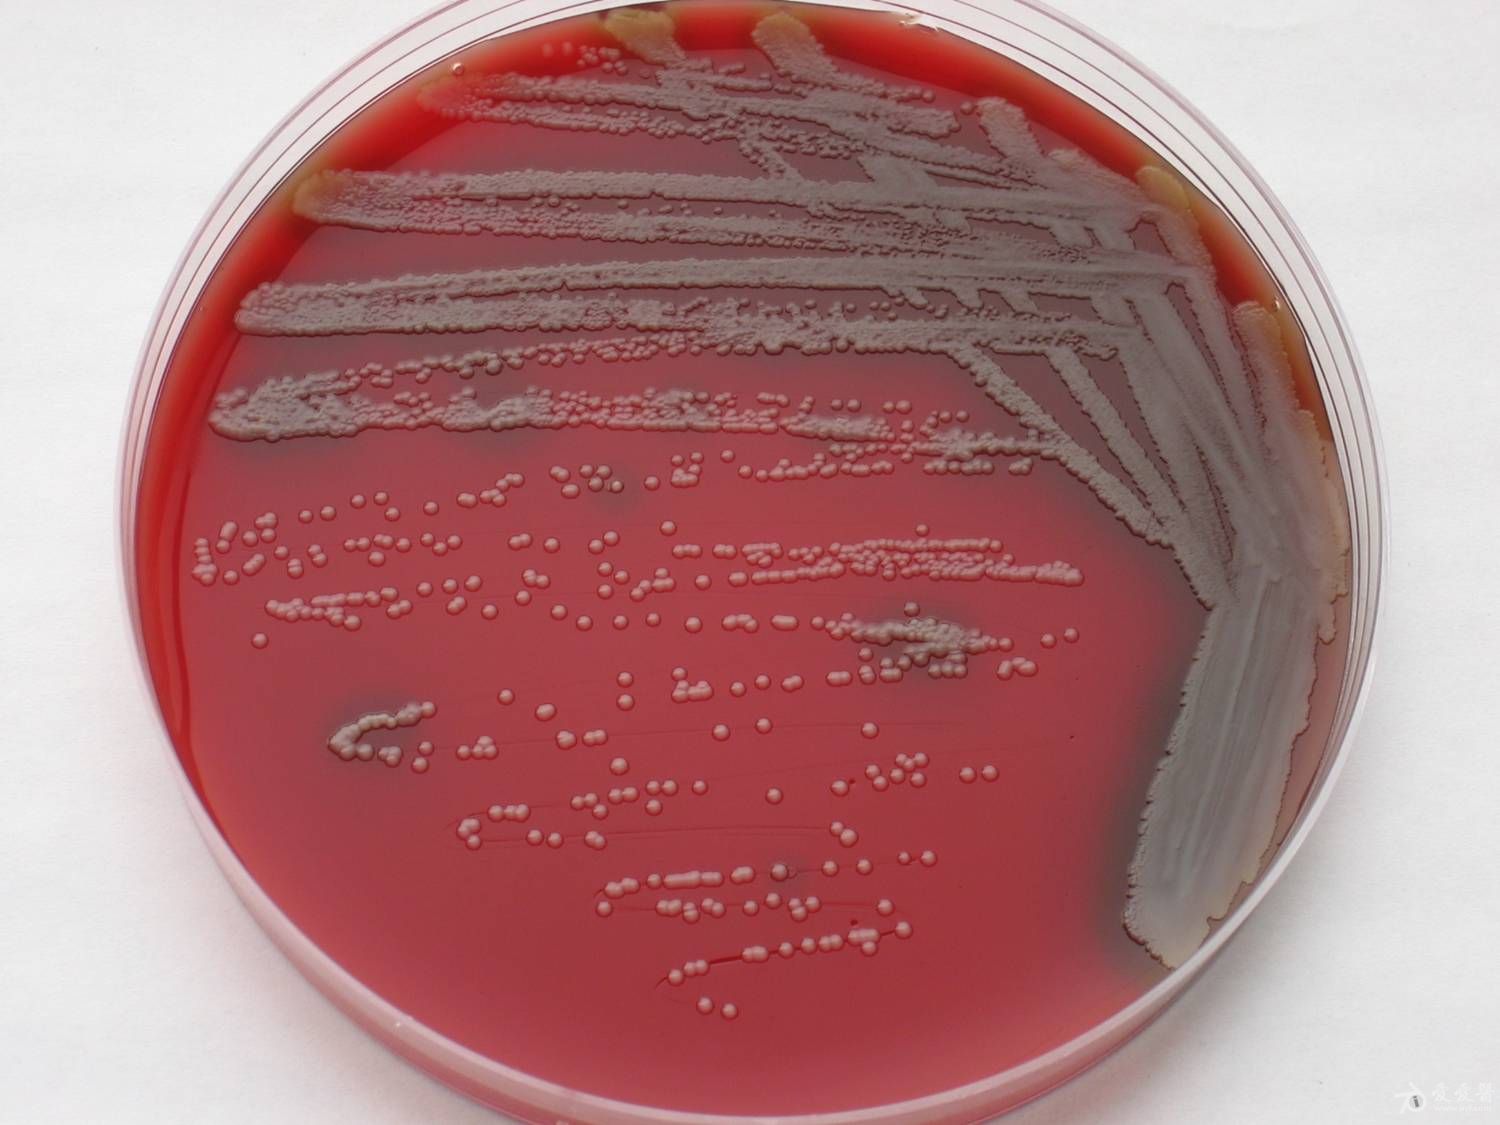
p>卡他莫拉菌(moraxella catarrhalis,简称mc) a target="_blank"
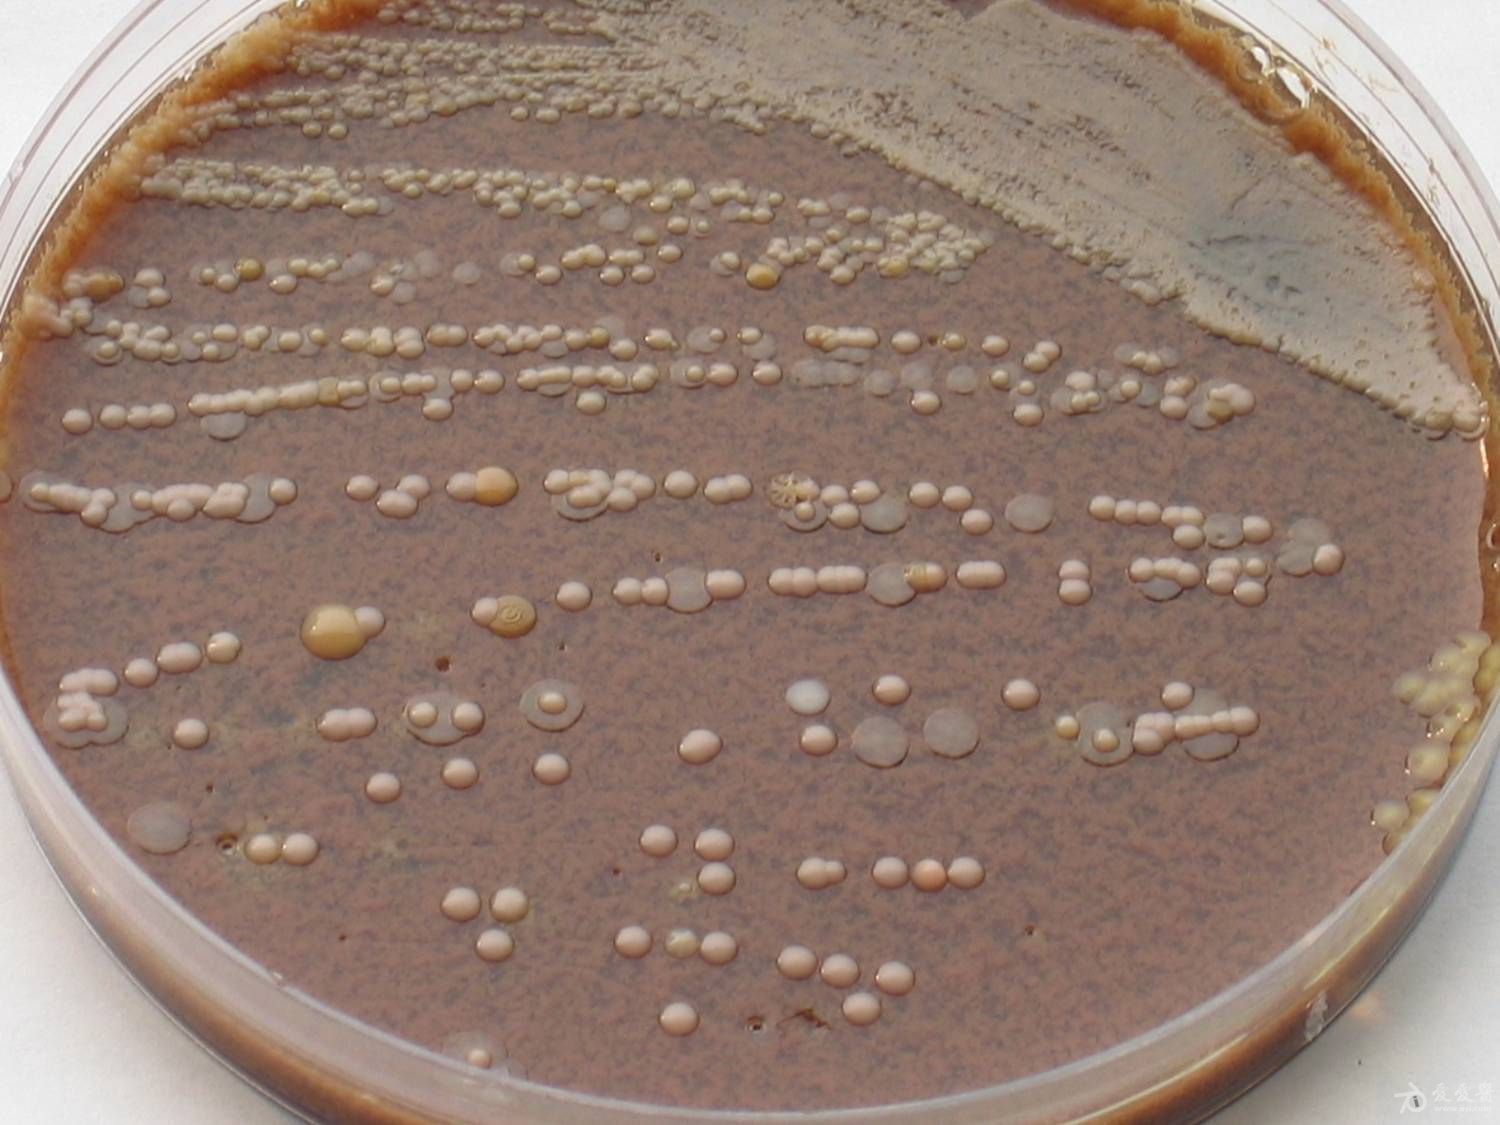
p>卡他莫拉菌(moraxella catarrhalis,简称mc) a target="_blank"

catarrhal

卡斯罗怎么训练?全面解读卡斯罗犬训练方法与技巧
图片尺寸640x956
2014年雪佛兰科尔维特黄貂鱼hpe700双涡轮增压.
图片尺寸2560x1600
卡斯罗犬甲状腺功能减退症
图片尺寸2000x1500
猛犬中只有卡斯罗具备这十大天性
图片尺寸5184x3456
从争议到关注,剪耳朵与裁尾的卡斯罗,卡斯罗犬为什么要剪耳朵?
图片尺寸640x960
从争议到关注,剪耳朵与裁尾的卡斯罗,卡斯罗犬为什么要剪耳朵?
图片尺寸640x960
雪佛兰科尔维特c7黄貂鱼,geigercars,汽车,护卫舰,调
图片尺寸1024x679
geigercars雪佛兰科尔维特c7黄貂鱼相关车壁纸750x1334分辨率查看
图片尺寸2560x1600
雪佛兰科尔维特黄貂鱼c7高清壁纸
图片尺寸1024x640
p>卡他莫拉菌(moraxella catarrhalis,简称mc) a target="_blank"
图片尺寸1600x1200
p>卡他莫拉菌(moraxella catarrhalis,简称mc) a target="_blank"
图片尺寸2000x1500
从争议到关注,剪耳朵与裁尾的卡斯罗,卡斯罗犬为什么要剪耳朵?
图片尺寸640x971
p>卡他莫拉菌(moraxella catarrhalis,简称mc) a target="_blank"
图片尺寸1575x1162
泰格豪雅卡莱拉系列calibre5自动腕表war211cfc6336
图片尺寸3000x3000
p>卡他莫拉菌(moraxella catarrhalis,简称mc) a target="_blank"
图片尺寸1500x1125
p>卡他莫拉菌(moraxella catarrhalis,简称mc) a target="_blank"
图片尺寸1500x1125
leopard,cat,predators,wildcat,boredom,paw,close
图片尺寸3008x2000
雪佛兰科尔维特c7黄貂鱼高清壁纸1366x768分辨率查看
图片尺寸1920x1080
car loading screens pack
图片尺寸4288x2848
download 1366x768 jaguar, predator, wild, big c
图片尺寸1366x768